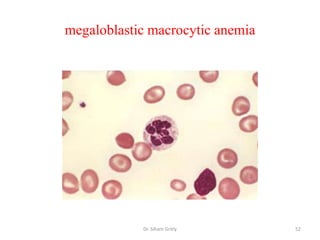
megaloblastic macrocytic anemia




            Dr. Siham Gritly      52

Vitamins serve as cofactors for enzymatic reactions by binding to enzymes to form active coenzyme complexes. Most B vitamins function as coenzymes involved in energy production and metabolism. Vitamin deficiencies can result in diseases; for example, thiamine deficiency causes beriberi and Wernicke-Korsakoff syndrome. Vitamins are essential for many cellular processes and metabolic reactions in the body.